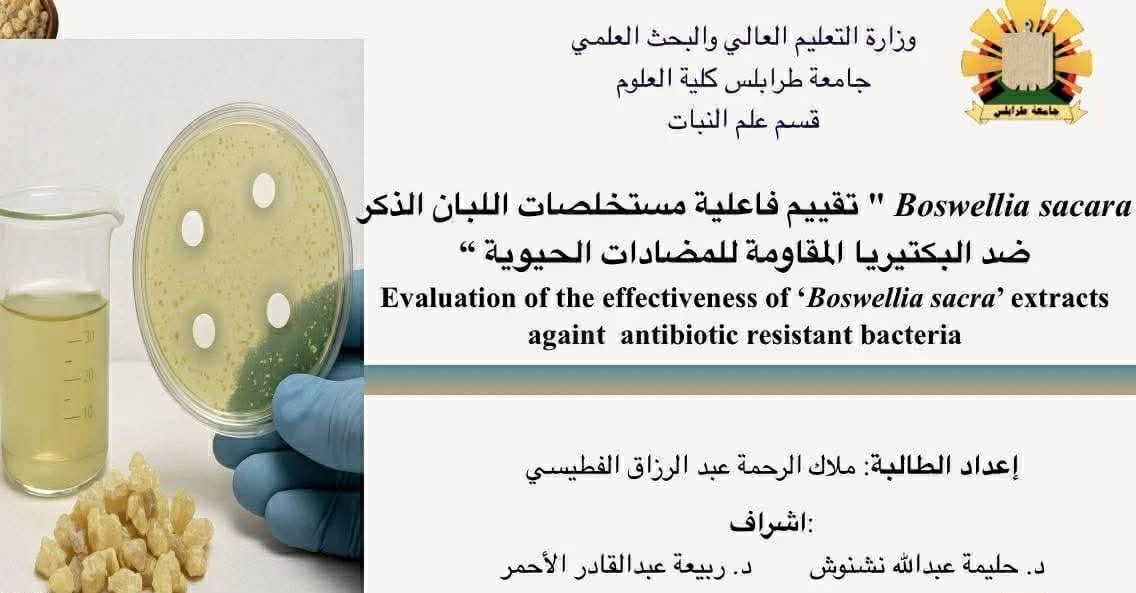

الجداول الدراسية لبرنامج اللغة بكلية العلوم لفصل الربيع 2026م
لقد قام مدير مكتب الدراسات العليا والتدريب بالكلية أ. د. خالد المرغني بالتنسيق مع مدير مركز اللغات بالجامعة د. أحمد قرقابة فى حصر المتقدمين لدراسة اللغة الانجليزية وتطوير المهارات اللغوية حسب رؤية جامعة طرابلس حيث تم توزيع الطلاب فى مستويات علمية مختلفة ويهدف البرنامج الى الاهتمام بفئة المعيدين واعضاء هيئة التدريس المنخرطين فى برامج الدراسات العليا بالاضافة الى طلاب الدراسات العليا ممن لم يتحصلو على المستويات المطلوبة لاعتماد خطة البحث.
ستكون الدراسة داخل اروقة كلية العلوم بالمبنى الرئيسي وبعض قاعات مبني الكيمياء. ونتقدم بجزيل الشكر للسيد وكيل الكلية للشئون العلمية أ. د. محمد عبد العزيز منصور و السيد رئيس قسم الدراسة والامتحانات بالكلية أ. أكرم ميلاد فى توفير القاعات المطلوبة وتنسيق الجدول بما يتلائم مع اغلب الطلاب.
ونهيب بجميع الطلاب بضرورة الالتزام بالحضور والمثابرة لما تمثله اللغات الحية من اهمية فى دراسة الماجستير والدكتوراة فى العلوم التطبيقية المختلفة.

التعليقات